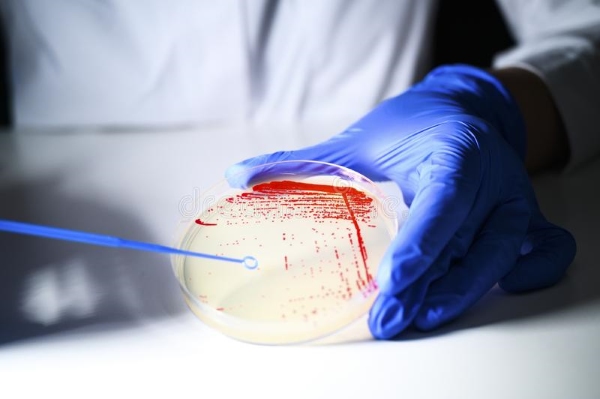
Đếm khuẩn lạc (CFU) là phương pháp định lượng phổ biến giúp kiểm soát vi sinh vật trong thực phẩm ở các dây chuyền sản xuất

Trong ngành công nghiệp chế biến và sản xuất, kiểm soát vi sinh vật trong thực phẩm không chỉ là yêu cầu kỹ thuật mà còn là yếu tố sống còn quyết định sự tồn tại của thương hiệu. Đối với các nhà quản lý chất lượng (QA/QC), việc thiết lập một hệ thống rào cản vững chắc để ngăn chặn các mối nguy sinh học là ưu tiên hàng đầu. Bài viết này của MT sẽ cung cấp các phương pháp thực tiễn để kiểm soát các tác nhân vi sinh, đảm bảo tuân thủ các tiêu chuẩn quốc tế khắt khe.
Vi sinh vật trong thực phẩm là gì?
Để thực hiện kiểm soát vi sinh vật trong thực phẩm thành công, trước hết chúng ta cần hiểu rõ “kẻ thù” và cả những “người bạn” trong thế giới vi mô này. Vi sinh vật trong thực phẩm bao gồm vi khuẩn, nấm (men, mốc), virus và ký sinh trùng.
Dựa trên tác động của chúng, có thể phân loại thành 3 nhóm chính:
- Vi sinh vật có lợi: Được sử dụng trong công nghệ lên men (sữa chua, phô mai, rượu vang, dưa muối). Ví dụ: Lên men Acid Lactic, Saccharomyces.
- Vi sinh vật gây hư hỏng: Không gây bệnh trực tiếp nhưng làm biến đổi màu sắc, mùi vị, kết cấu thực phẩm, gây thiệt hại kinh tế. Ví dụ: Nấm mốc, vi khuẩn Pseudomonas.
- Vi sinh vật gây bệnh (Pathogens): Là mục tiêu chính của kiểm soát nhiễm bẩn vi sinh vật. Nhóm này có thể gây bệnh ngay cả với số lượng nhỏ. Các loại vi sinh vật gây bệnh điển hình bao gồm:
- Salmonella: Thường gặp trong trứng, thịt gia cầm.
- E. coli (đặc biệt là O157:H7): Có trong thịt bò chưa nấu chín, rau sống, nước nhiễm khuẩn.
- Listeria monocytogenes: Cực kỳ nguy hiểm vì có thể phát triển ở nhiệt độ lạnh (tủ lạnh), thường gặp trong thịt nguội, phô mai mềm.
Một thách thức lớn trong vệ sinh dây chuyền sản xuất là sự hình thành biofilm trong thực phẩm. Đây là màng sinh học do vi khuẩn tiết ra để bảo vệ chúng khỏi các chất tẩy rửa và sát khuẩn, tạo thành ổ nhiễm khuẩn dai dẳng khó loại bỏ nếu chỉ vệ sinh thông thường.

Các phương pháp định lượng vi sinh vật phổ biến
Để đánh giá hiệu quả của quy trình kiểm soát vi sinh vật trong thực phẩm, các phòng thí nghiệm cần áp dụng các phương pháp định lượng chuẩn xác. Dưới đây là các phương pháp cơ bản thường được quy định trong ISO 7218 và các TCVN tương ứng.
Phương pháp đếm trực tiếp (Direct Microscopic Count)
Phương pháp này sử dụng kính hiển vi để quan sát tế bào vi sinh trong mẫu nhằm ước lượng nhanh mật độ vi sinh. Cách làm này đặc biệt hữu ích trong các bước đánh giá ban đầu tại hiện trường.
- Ưu điểm: Thời gian phân tích ngắn, chi phí thấp, kết quả nhận được ngay.
- Nhược điểm: Không phân biệt được tế bào còn sống hay đã chết nếu thiếu thuốc nhuộm; mẫu có mật độ vi sinh thấp sẽ khó quan sát.
- Ứng dụng: Kiểm tra nguyên liệu trước chế biến, giám sát nhanh mức độ ô nhiễm vi sinh trong sản xuất.
Phương pháp đếm khuẩn lạc (Plate Count – CFU)
Ở kỹ thuật này, mẫu được pha loãng rồi cấy lên môi trường thạch để các tế bào sống hình thành khuẩn lạc. Đây là phương pháp định lượng phổ biến giúp kiểm soát vi sinh vật trong thực phẩm ở các dây chuyền sản xuất.
- Ưu điểm: Chính xác, đặc hiệu cho vi sinh vật sống và áp dụng rộng rãi cho nhiều nhóm vi sinh khác nhau.
- Nhược điểm: Thời gian ủ dài, quy trình thao tác đòi hỏi môi trường phòng lab đạt chuẩn.
- Ứng dụng: Định lượng tổng số vi sinh hiếu khí, nấm men, nấm mốc và các chỉ thị vệ sinh theo tiêu chuẩn ISO.
Phương pháp MPN (Most Probable Number)
MPN xác định mật độ vi sinh bằng việc cấy mẫu vào các ống môi trường lỏng ở nhiều mức pha loãng và đọc kết quả dựa trên số ống dương tính. Khi thực hiện kiểm soát vi sinh vật trong thực phẩm, cách tiếp cận bằng MPN phù hợp cho các mẫu khó xử lý hoặc chứa ít vi sinh .
- Ưu điểm: Phân tích tốt các mẫu khó xử lý, thao tác dễ và không yêu cầu tách lọc nhiều.
- Nhược điểm: Giá trị ước tính mang tính thống kê nên độ chính xác không cao bằng phương pháp khuẩn lạc; thời gian trả kết quả lâu.
- Ứng dụng: Thường dùng cho Coliforms, E. coli và Fecal coliforms trong nước, sữa và các sản phẩm có nguy cơ nhiễm vi sinh đường ruột.
Đọc thêm:
Các phương pháp kiểm soát vi sinh vật trong thực phẩm
Trong ngành công nghiệp thực phẩm, việc áp dụng đúng phương pháp xét nghiệm vi sinh là nền tảng để đảm bảo an toàn và giảm thiểu rủi ro ô nhiễm. Dựa trên đặc điểm của từng kỹ thuật kiểm nghiệm, bạn có thể lựa chọn các phương pháp như:
Phương pháp nuôi cấy
Phương pháp nuôi cấy được coi là “tiêu chuẩn vàng” trong kiểm nghiệm vi sinh thực phẩm, dựa trên khả năng tăng sinh và hình thành khuẩn lạc của vi sinh vật sống trong môi trường phòng thí nghiệm. Kỹ thuật này cung cấp thông tin chi tiết về chất lượng, số lượng và chủng loại vi sinh có trong mẫu thực phẩm.
Quy trình thực hiện:
- Tiền tăng sinh: Khuếch đại số lượng vi sinh vật trong mẫu.
- Tăng sinh chọn lọc: Nuôi vi sinh vật trên môi trường thích hợp để loại bỏ tạp chất và ưu tiên các nhóm mục tiêu.
- Nuôi cấy trên môi trường chọn lọc: Hình thành khuẩn lạc dễ quan sát và đếm.
- Xác nhận cuối cùng: Kiểm nghiệm sinh hóa hoặc huyết thanh để định danh chính xác vi sinh vật.
Ưu điểm:
- Độ nhạy cao, xác định được vi sinh vật sống.
- Chi phí thấp, thao tác đơn giản, dễ áp dụng trong phòng thí nghiệm.
Nhược điểm:
- Quy trình tốn nhiều thời gian, thường khoảng 1 tuần để hoàn thiện toàn bộ các bước.
- Sự phân bố không đồng đều của vi sinh vật và hiện diện của các vi sinh bản địa có thể ảnh hưởng đến độ chính xác.
- Hiệu quả hạn chế với vi sinh vật bị tổn thương hoặc ở trạng thái VBNC (Viable But Non-Culturable).
Phương pháp nuôi cấy vi sinh vật vẫn là nền tảng quan trọng trong hệ thống kiểm soát vi sinh vật trong thực phẩm. Đặc biệt là ở các bước xác định chất lượng nguyên liệu và đánh giá vệ sinh tổng thể.

Phương pháp không nuôi cấy
Để khắc phục hạn chế về thời gian của kỹ thuật truyền thống, nhiều phương pháp không nuôi cấy đã được phát triển, đặc biệt là nhóm xét nghiệm dựa trên nucleic acid và dựa trên thực khuẩn thể (phage). Đây là những hướng tiếp cận mang lại tốc độ nhanh hơn, phù hợp khi cần phản ứng kịp thời trong các chương trình kiểm soát vi sinh vật trong thực phẩm.
Phương pháp dựa trên nucleic acid
Kỹ thuật PCR và các biến thể (qPCR, LAMP) giúp phát hiện DNA/RNA của vi sinh vật với độ nhạy và đặc hiệu cao. Viability PCR (vPCR) còn được cải tiến bằng EMA hoặc PMA nhằm phân biệt tế bào sống với tế bào chết dựa trên tính toàn vẹn màng tế bào. Tuy nhiên, các phương pháp này vẫn có thể gây âm tính hoặc dương tính giả trong trường hợp tế bào tổn thương hoặc mRNA bị phân hủy (đối với RT-PCR).
Nhìn chung, nhóm phương pháp này phù hợp khi cần kết quả nhanh trong giám sát mối nguy, đặc biệt ở công đoạn kiểm soát mầm bệnh.
Phương pháp dựa trên bacteriophage
Phage có tính đặc hiệu cao và chỉ xâm nhiễm lên vi khuẩn sống, vì vậy được xem là giải pháp nhiều triển vọng trong xét nghiệm vi sinh thực phẩm. Phương pháp plaque assay dựa trên sự hình thành vết tan để ước tính nồng độ vi khuẩn, trong khi các kỹ thuật qPCR hoặc miễn dịch sử dụng phage theo dõi sự tăng sinh sau khi ly giải tế bào.
Các xét nghiệm này có thể cho kết quả trong 4–8 giờ, nhanh hơn đáng kể so với nuôi cấy truyền thống. Tuy vậy, yêu cầu kỹ thuật cao trong việc loại phage ngoại bào và kiểm soát quy trình có thể làm tăng độ phức tạp khi triển khai ở quy mô phòng kiểm nghiệm.

Tóm lại, kiểm soát vi sinh vật trong thực phẩm giữ vai trò trung tâm trong bảo đảm an toàn, nâng cao chất lượng và duy trì uy tín cho doanh nghiệp sản xuất. Áp dụng đúng phương pháp xét nghiệm giúp phát hiện sớm nguy cơ, giảm rủi ro ô nhiễm và hỗ trợ quá trình đánh giá tuân thủ theo tiêu chuẩn quốc tế. Nhờ đó, hệ thống quản lý chất lượng vận hành ổn định và bền vững hơn.
Trong thực tế sản xuất, việc kiểm soát vi sinh hiệu quả cần được hỗ trợ bởi hệ thống lên men và hệ thống nuôi cấy Bioreactor đạt chuẩn, giúp kiểm soát môi trường phát triển của vi sinh vật và duy trì sự ổn định của quy trình. Bên cạnh đó, máy lên men vi sinh fermenter đóng vai trò quan trọng trong việc kiểm soát các thông số như nhiệt độ, pH và nồng độ oxy hòa tan, từ đó nâng cao độ chính xác và khả năng lặp lại của kết quả.
Song song với quá trình nuôi cấy, các giải pháp xử lý và tinh lọc như housing lọc và lọc tiếp tuyến giúp loại bỏ tạp chất, vi sinh không mong muốn và bảo toàn hoạt tính sản phẩm. Hệ thống vận chuyển chất lỏng trong dây chuyền cũng cần đến bơm ly tâm GEA nhằm đảm bảo lưu lượng ổn định, vận hành an toàn và đáp ứng các yêu cầu nghiêm ngặt về vệ sinh trong ngành thực phẩm và công nghệ sinh học.
Liên hệ MT để được tư vấn giải pháp phù hợp nhất cho dây chuyền sản xuất của bạn.
- Địa chỉ: TK40/10 Đường Trần Hưng Đạo, Phường Cầu Ông Lãnh, TP. Hồ Chí Minh, Việt Nam
- Hotline: 0767 067 567
- Email: infor@mtenequip.com



